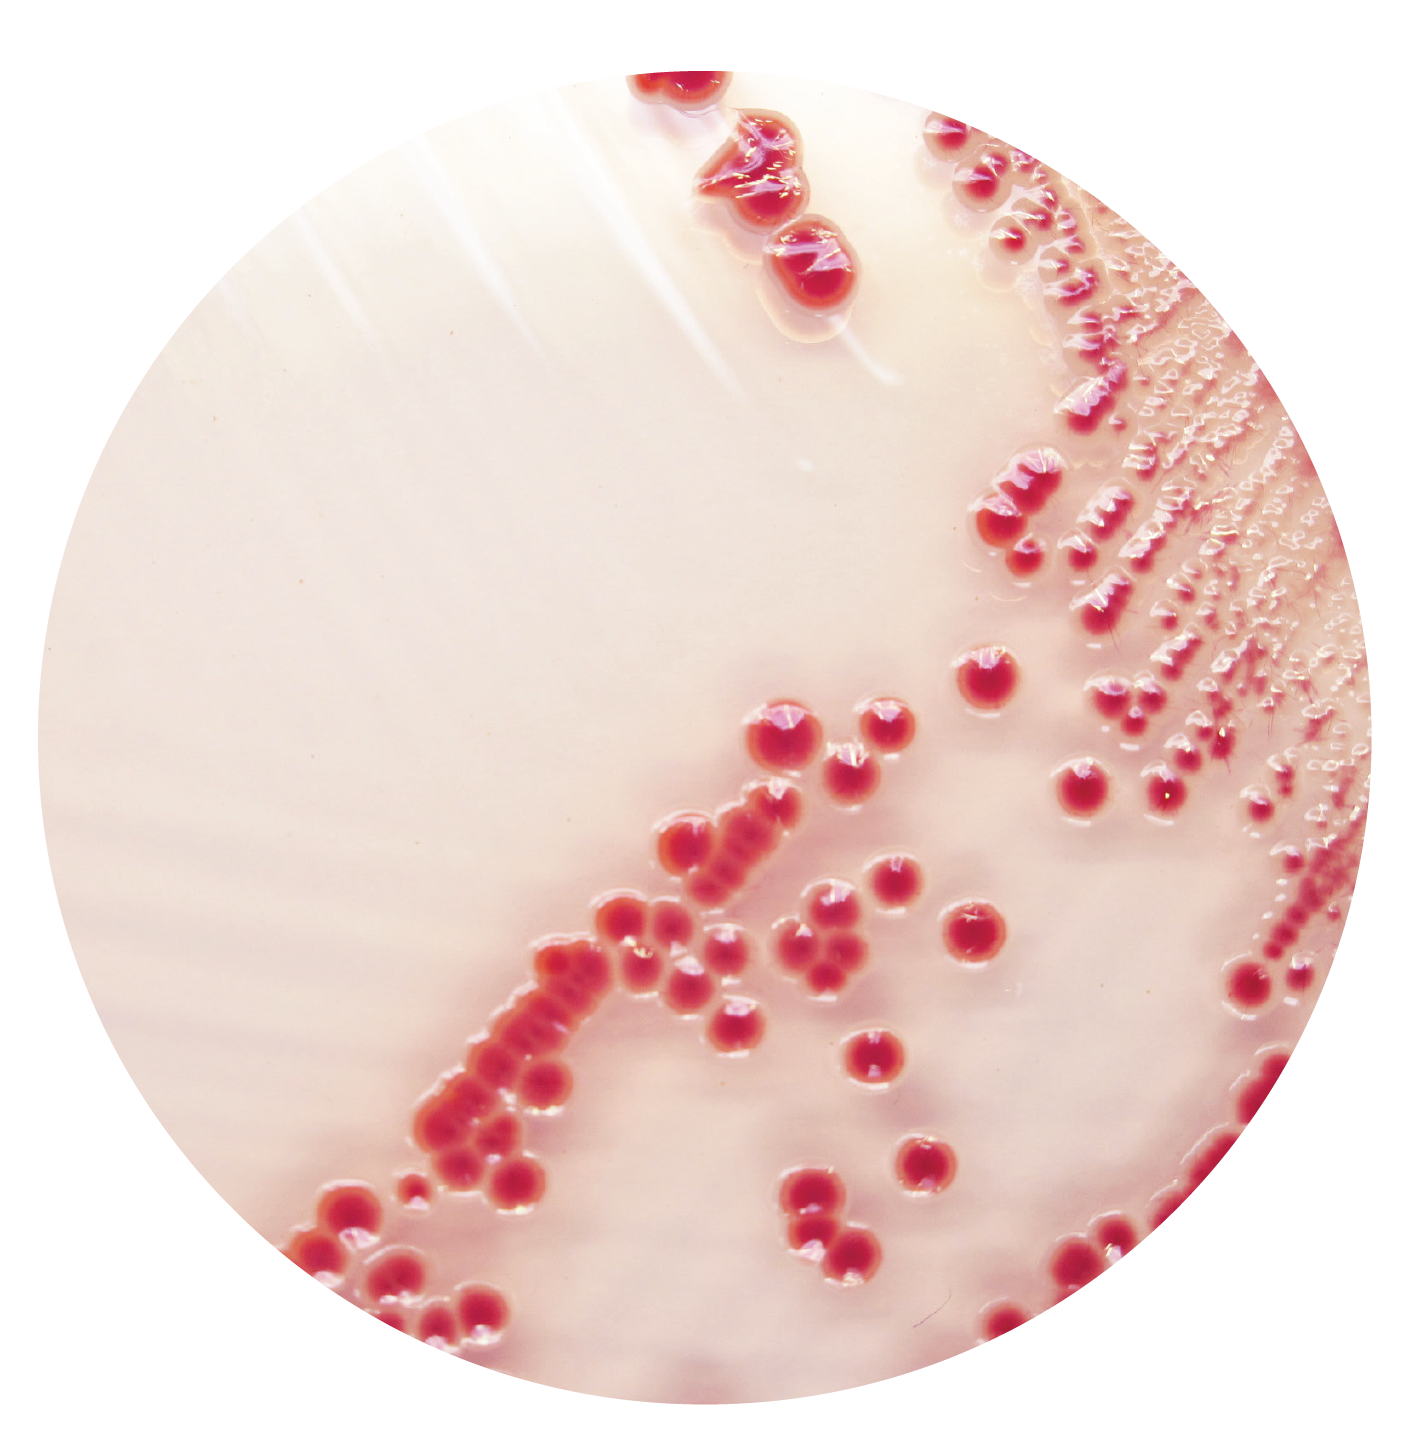
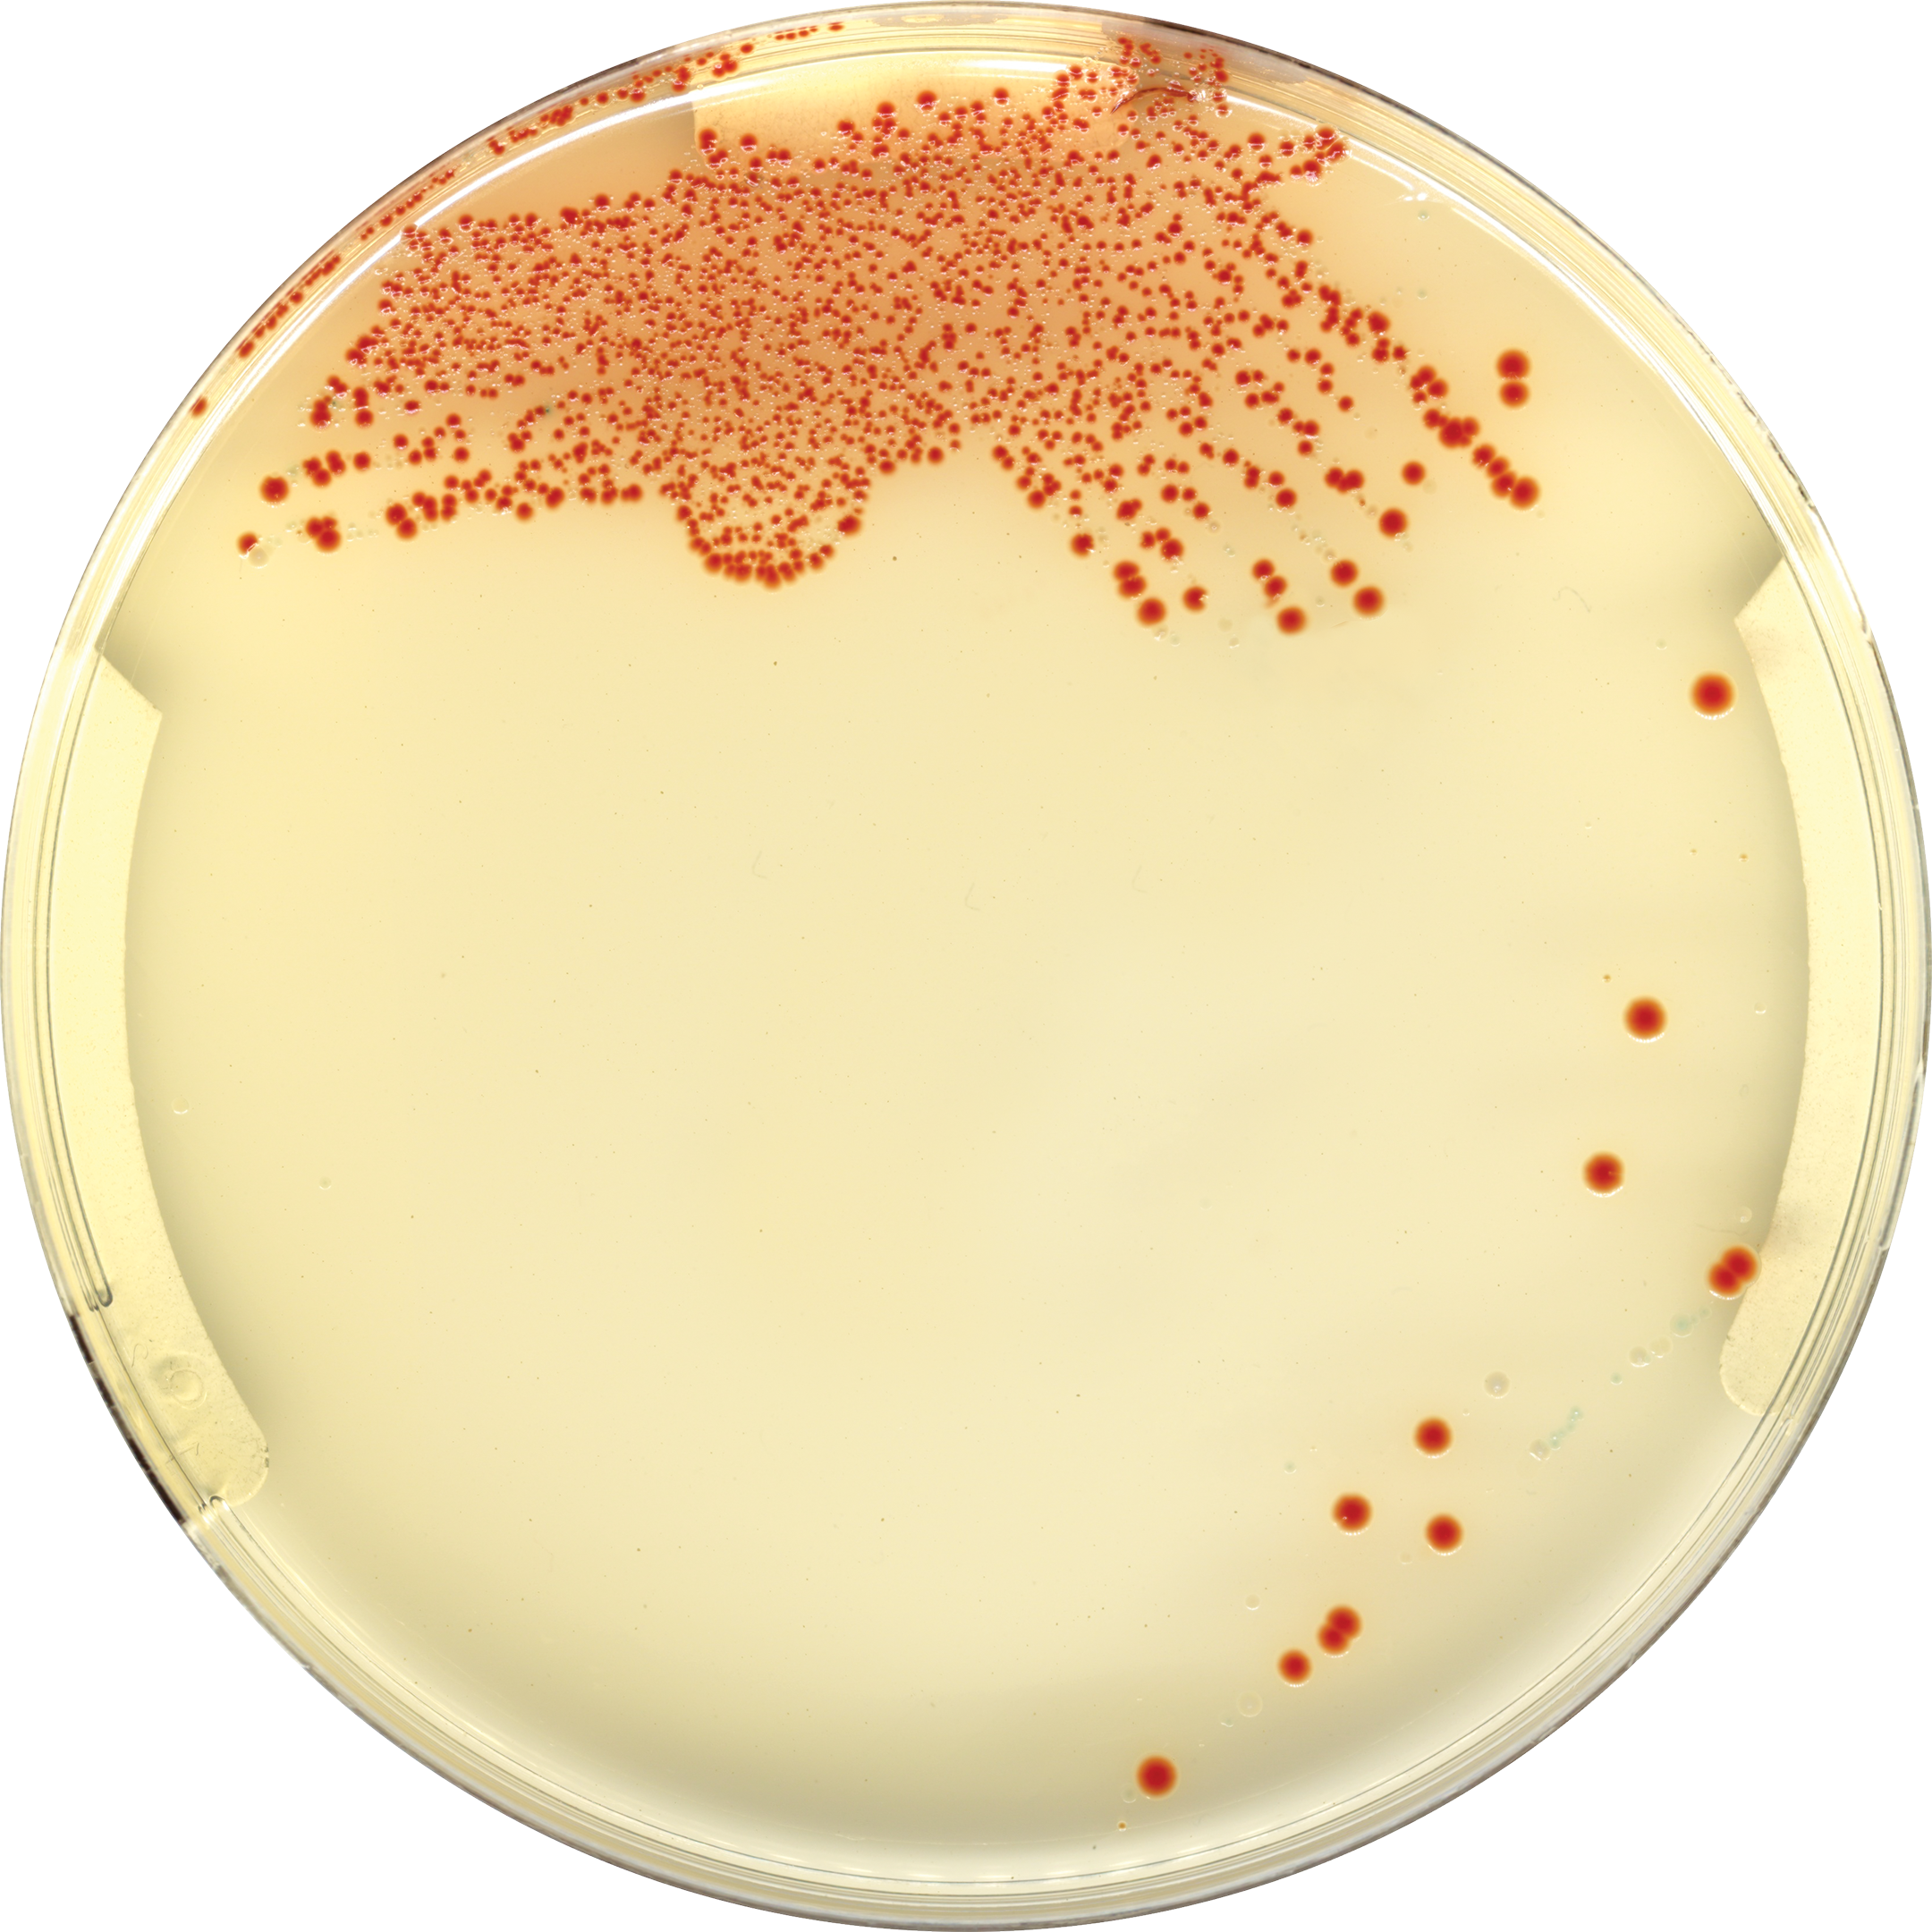
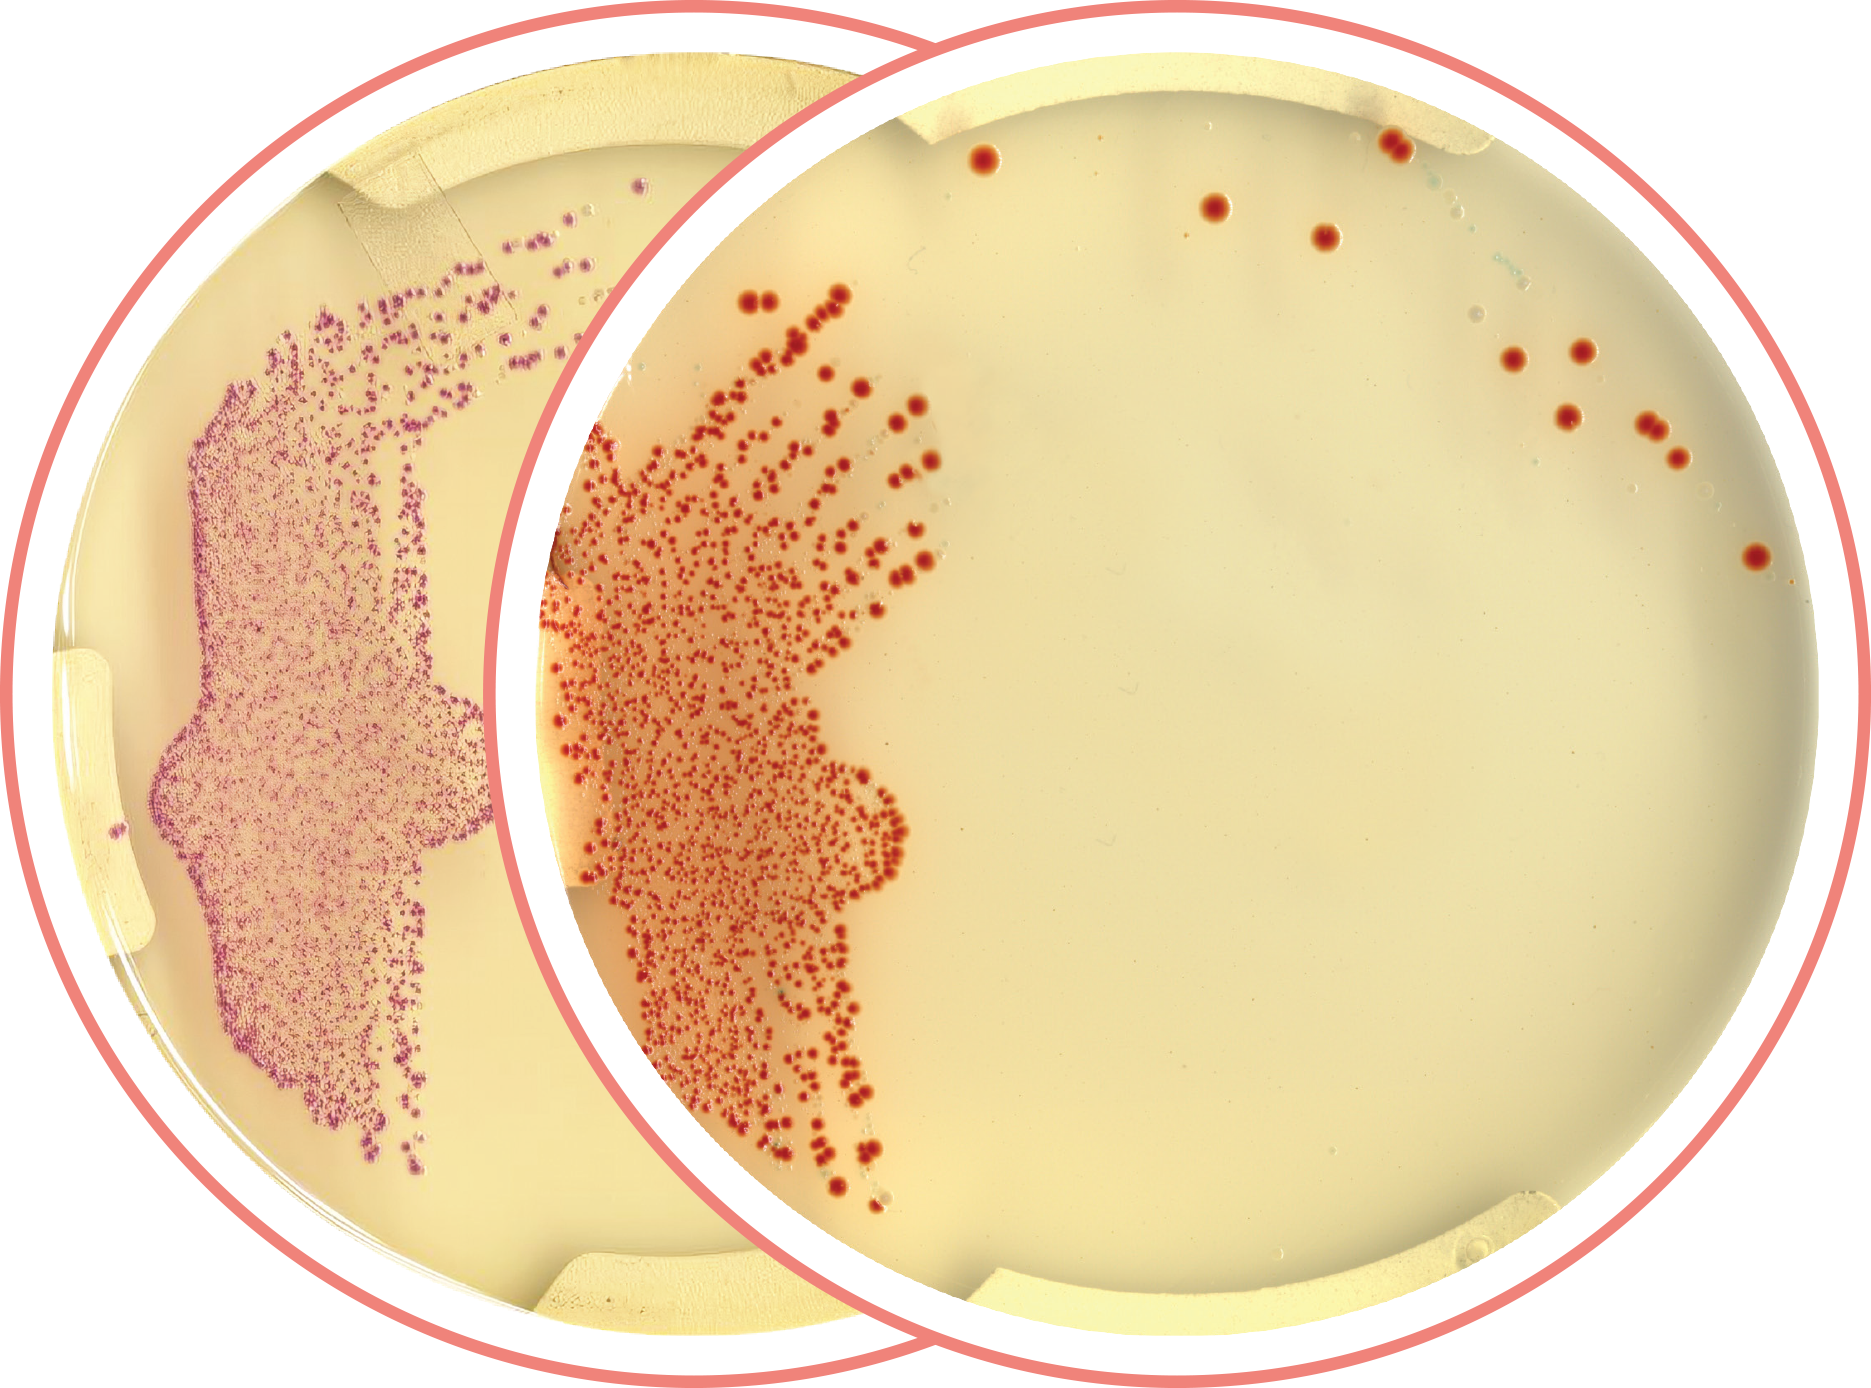

Our Products

COLOREX™ Candida Plus
For detection and differentiation of major clinical Candida species, including C. auris
COLOREX™ Candida Plus is the first prepared chromogenic isolation medium that uses CHROMagar™ powders to detect and differentiate C. auris, in addition to other major clinical Candida species such as C. albicans, C. tropicalis, C. glabrata, or C. krusei.
COLOREX™ Acinetobacter
For detection and isolation of Acinetobacter species and MDR Acinetobacter
First in its class, COLOREX™ Acinetobacter is designed as a highly selective and differential chromogenic prepared medium made with CHROMagar™ powders. It allows the growth of Acinetobacter in striking red colonies, after overnight incubation. Its intended for use in the qualitative direct detection of colonization with Acinetobacter to aid in the prevention and control of Acinetobacter, drug-susceptible or multi-drug resistant (MDR), in healthcare settings.
COLOREX™ B.cepacia
For detection and numeration of Burkholderia cepacia complex

COLOREX™ B.cepacia is designed as a highly selective and differential chromogenic prepared medium for detection and enumeration of Burkholderia cepacia complex (BCC). BCC colonies develop with an intense green-blue colony color, clearly visible to the naked eye. BCC is among the most important pathogens isolated from cystic fibrosis patients and in hospital acquired infections. The pathogen causes life-threatening infections in cystic fibrosis patients associated with pulmonary function decline.
COLOREX™ StrepA
For screening and detection of Group A Streptococci in throat swab samples
COLOREX™ StrepA is a chromogenic formulation, that uses CHROMagar™ powders, for easy to read and straight forward color differentiation of Group A streptococcal (GAS) colonies. GAS colonies are orange to red, while other bacteria in the complex throat flora are blue or colorless.
COLOREX™ StrepACG
For screening and detection of Group A, Group ACG Streptococci in throat swab samples
COLOREX™ StrepACG is a chromogenic formulation, that uses CHROMagar™ powders, for easy to read and straight forward color differentiation of Group A streptococcal (GAS), and Group C/G streptococci colonies. With COLOREX™ StrepACG, these streptococci are colored in orange to red /dark purple to brown.
COLOREX™ Urine Orientation
For isolation and differentiation of urinary tract pathogens

COLOREX™ Orientation is a non-selective chromogenic culture medium, using CHROMagar™ powders, intended for use in the qualitative direct detection, differentiation and presumptive identification of uropathogens to aid in the diagnosis of urine tract infections.
COLOREX™ mSuperCARBA™
For detection and isolation of Carbapenem-resistant Enterobactereales (CRE) *Research Use Only

COLOREX™ mSuperCARBA™ is a selective and differential chromogenic prepared culture medium, manufactured using CHROMagar™. It is intended for use in the qualitative direct detection of gastrointestinal colonization with carbapenem-resistant Enterobacteria (CRE), including OXA-48 producers, to aid in the prevention and control of CRE in healthcare settings. The test is performed with rectal swab and stools from patients to screen for CRE colonization. Results can be interpreted after 18-24 h of aerobic incubation at 35-37 °C.
